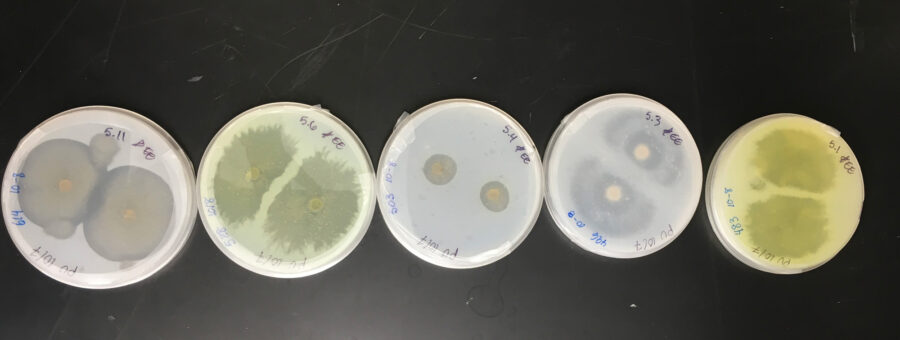
Marine Fungi

A group of scientists are investigating the possibility that marine fungi could be used to break down polyurethane.
| 
							 Listen To This Story 
							 | 
						
On average, Americans eat, drink, inhale, and absorb through their skin a credit card’s worth of microplastics each week. And, because these tiny particles don’t naturally dissolve in the body, this is a serious problem that is linked to various health issues, including cancer and reproductive disorders. Now, however, researchers have found a possible solution: While human bodies cannot break down these microplastics, certain marine fungi can. And not only that, they can even be “taught” to consume more of them at a faster rate.
Although plastics make our lives easier, their nondegradable nature has significant downsides. While the main one was long believed to be the trash that plastics generate, we now know that tiny plastic particles are infiltrating our food chain and jeopardizing human health.
In light of these problems, efforts to reduce the effects of plastics are already underway. Students at the University of Hawaii at Mānoa have recently taken a small but crucial step in the fight against plastic, demonstrating a possible new and more sustainable approach to waste management.
In her honors thesis project, senior Ronja Steinbach explored diverse species of fungi in the ocean and their ability to degrade plastic.
“Not only is [plastic] a pollutant, but it is also a ‘habitat’ growing faster than anything else,” said Steinbach. “Where coral reefs are declining and the [open ocean] space is staying the same, a plastic ‘habitat’ space is growing.” The most famous example is the Great Pacific Garbage Patch.
But hope also floats in our oceans in the form of marine fungi.
Steinbach’s project reveals that a few strains of marine fungi have a taste for polyurethane, one of the world’s most widely used plastic materials.
Polyurethane, also known as PU, is made up of organic compounds, such as hydrocarbons, that can be broken down into smaller elements, including carbon, an essential nutrient for fungi that utilize it as an energy source.
Steinbach was curious to investigate the role marine fungi might play in mitigating the consequences of plastic contamination, an area of study that lacks prior research. The perfect opportunity to test Steinbach’s hypothesis arose when PhD marine biology student Syrena Whitner, co-author of this study, was also working in the lab, exploring other abilities that various groups of marine fungi possess.
Whitner composed a library of samples for her work that aligned seamlessly to provide Steinbach with her own assortment. Overall, the team collected 68 fungal samples from Hawaii’s nearshore ecosystems, placed them in petri dishes, and introduced a polyurethane solution to observe if and how fast the fungi could consume it.
The researchers discovered that nearly two-thirds of the samples could break down the plastic by releasing enzymes that chemically decompose the compounds and turn them into more fungi. This discovery led to the second stage of the experiment, which consisted of conditioning the fastest degraders to “eat” the polyurethane more efficiently by increasing the percentage of the solution.
Starting with the original 1 percent PU concentration, they increased it gradually to 12 percent. Three fungi increased their feeding rates to 15 percent within three months.
Although the data is promising, the work here is just getting started. Now, the researchers are grappling with various unknowns and more questions. For example, how do these in vitro findings translate into solving real-world problems?
“When we think about a larger-scale application of this, we can’t just sprinkle super fungi into the ocean and just expect this plastic problem to go away,” said Steinbach.
Rather, the takeaway is that marine fungi have genes responsible for producing the enzymes that break down plastic. The researchers are interested in exploring appropriate ecological and fiscal applications of this enzyme. They are especially curious if it could be mass-produced or used topically. However, there is little research available on marine fungi, and the research team lacks the necessary resources to conduct additional large-scale experiments.
Marine fungi may be worth further study, however, not only because they offer a potential for safer plastic disposal, but also because they show promise for the future of medicine. Before this research began, Whitner was working with a biotech company to explore the biomedical side of marine fungi’s superpowers for natural product drug discovery.
“Fungi are very good at degrading things, but they also produce a lot of cool secondary metabolites that people can use for anti-cancer, anti-inflammatory compounds,” said Whitner.
Unlocking the solution to plastic contamination may seem like a no-brainer, but researchers can only do so much with the tools and current knowledge available to them, Whitner explained. Marine fungi have great potential to revolutionize not only waste management, but also support the well-being of humans and wildlife.
“I think a lot of people don’t even realize the fact that marine fungi exist, and so if anything, just that little tidbit of knowledge is something that I would love for people to come away with,” said Steinbach.
		 
